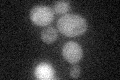

View description
Bifunctional dehydrogenase and ferrochelatase, involved in the biosynthesis of siroheme, a prosthetic group used by sulfite reductase; required for sulfate assimilation and methionine biosynthesis
Localization:
Intensity:
Fold change:
Significance:
-
C’ GFP library in SD
below threshold16.61 -
N' NOP1pr-GFP in SD

cytosol70.9047 -
N' TEF2pr-mCherry in SD

cytosol111.678 -
N' NATIVEpr-GFP in SD

below threshold23.3962 -
N' TEF2pr-VC and Cyto-VN in SD

#N/A0 -
C’ GFP library in SD+DTT

cytosol17.51.05No -
C’ GFP library in SD+H2O2

cytosol17.421.04No -
C’ GFP library in Starvation Media

cytosol17.321.04No -
C’ GFP library on the background of Pup2-DaMP

below threshold -
C’ GFP library on the background of CCT mutant

below threshold17.38921.04648No
